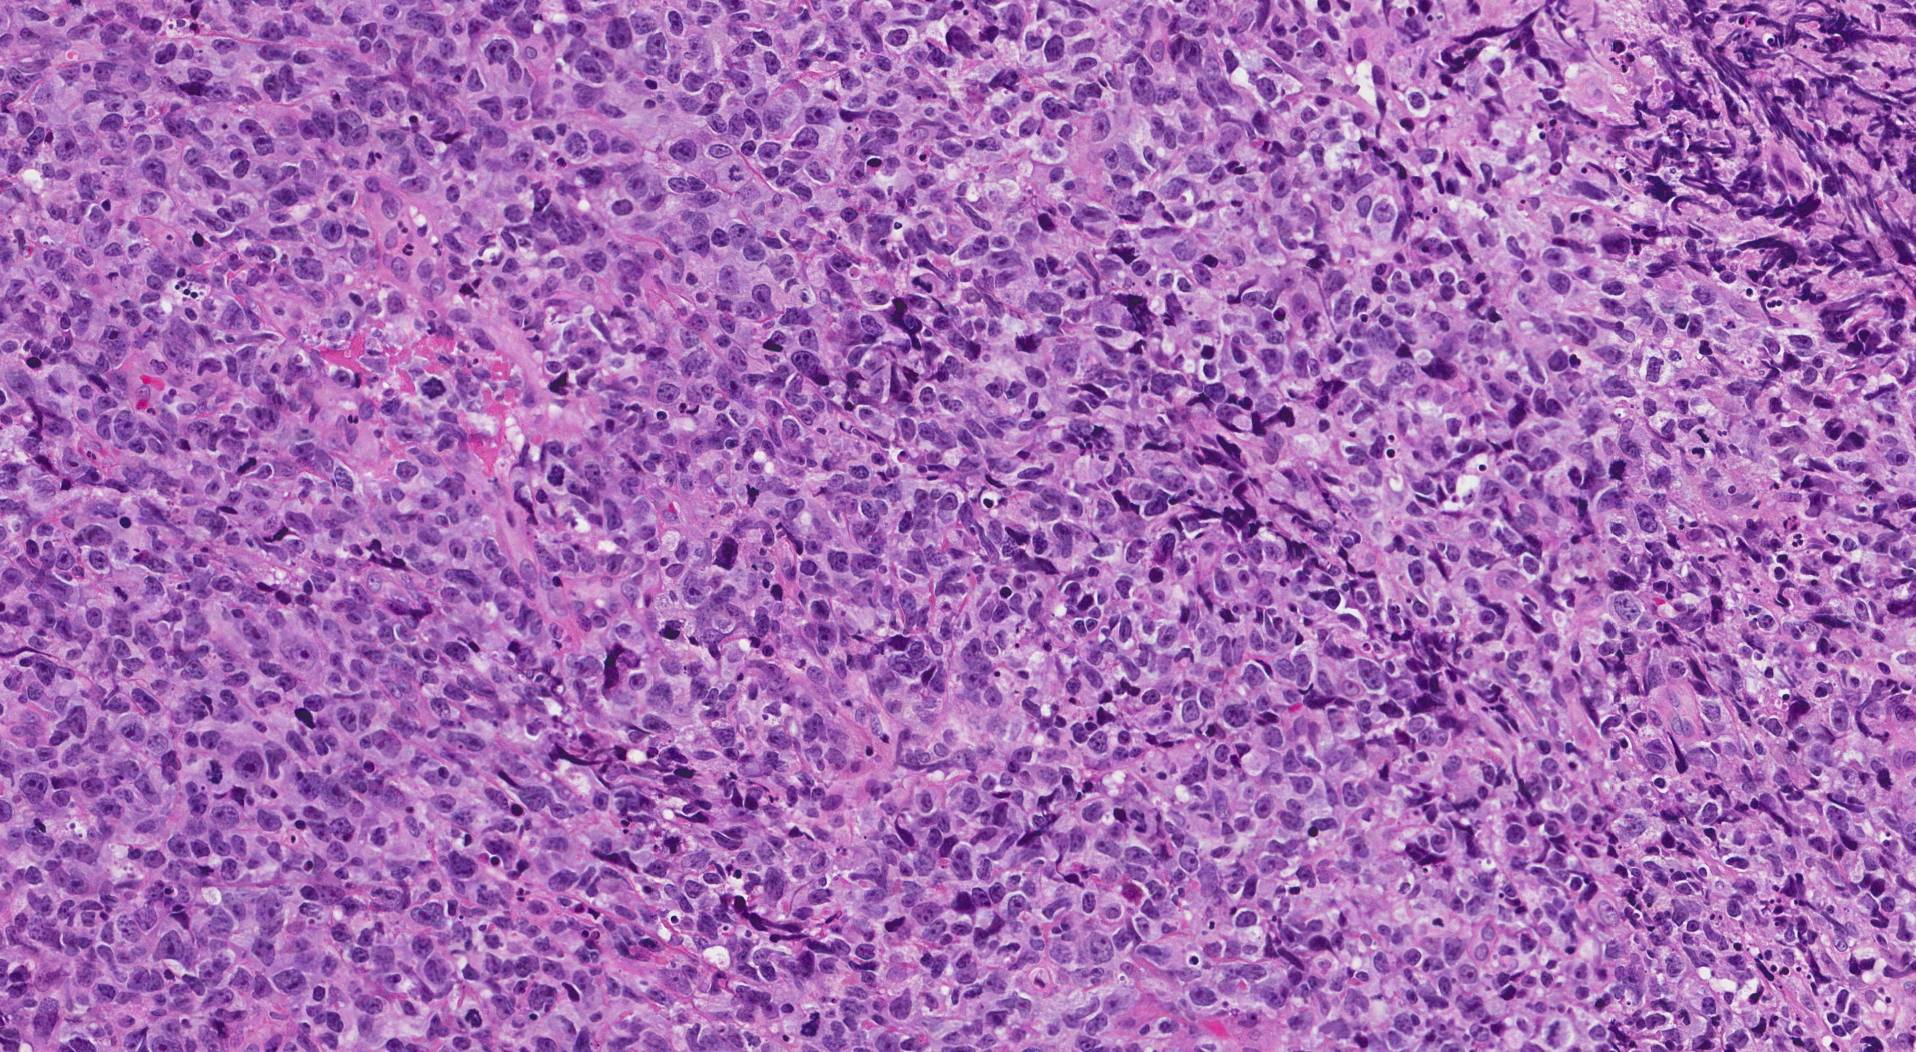
喉の扁平上皮癌の症状は何ですか?

喉の扁平上皮がんは、喉の内側を覆う細胞で発生する頭頸部がんの一種です。気管、扁桃腺、または発声器に発生する場合があります。
喉の扁平上皮癌は扁平上皮細胞で発生します。扁平上皮細胞は、皮膚、口、喉の内層を構成する平らで薄い細胞です。
扁平上皮癌 咽頭癌は喉のあらゆる領域に影響を与える可能性があります。医師は喉の扁平上皮癌を喉内の部位によって分類する場合があります。
この記事では、扁平上皮癌咽頭癌について、原因、症状、治療法などについて説明します。
医師たちは喉の扁平上皮癌の正確な原因を知りません。しかし、彼らはリスクを高める可能性のある特定の要因を特定しました。
考えられる危険因子には次のようなものがあります。
- タバコを吸う
- アルコールの多量使用
- 米国の中咽頭がんの最大 70% を占めるヒトパピローマウイルス (HPV) 感染症
- 喉頭がんまたは下咽頭がん患者の半数以上が診断時に65歳以上であるため、年齢
- 性別、これらの種類のがんは男性で最大 5 倍一般的であるため
咽頭がんの危険因子について懸念がある場合は、医師に相談できます。
喉の扁平上皮癌の症状は、喉の正確な位置によって異なります。
考えられる症状は次のとおりです。
- 話す、噛む、飲み込むのが難しい
- 呼吸困難
- 喉に何か詰まっているような感じ
- 喉の痛みが治まらない
- 喉のしこり
- 喉の潰瘍
- 血まみれの粘液
- 嗄れ声
- 耳鳴りがする
- 耳の痛み
これらの症状にはさまざまな原因が考えられます。医師は、がんや他の病気が原因であるかどうかを判断するための検査を指示できます。
医師はさまざまな方法を組み合わせて咽頭扁平上皮癌を診断します。
通常、最初のステップは身体検査です。医師はまた、患者の症状について質問し、完全な病歴を尋ねることもあります。
医師は喉の内部を観察するために内視鏡検査や喉頭鏡検査を行うこともあります。また、組織サンプルを採取して分析のために研究室に送る生検も行います。
画像検査は診断に役立ち、状態の程度を判断することができます。これらのテストには次のものが含まれます。
- CTスキャン
- 超音波
- MRI
医師は、どの検査を指示するのか、またその内容について説明します。
咽頭扁平上皮がんの治療は、がんの段階と転移の有無によって異なります。医師は患者の状態に基づいて治療法を推奨し、適切な治療計画の作成を支援します。
通常、咽頭扁平上皮がんの主な治療法は、がんを切除する手術と放射線療法の 2 つです。放射線療法では、腫瘍を標的とした線量の放射線を照射してがん細胞を死滅させます。
医師は化学療法を勧めることもあります。化学療法には、がん細胞を破壊するさまざまな種類の薬剤が含まれます。
現在、臨床試験では、免疫療法や標的療法などの他の治療法が研究されています。
免疫療法治療には、免疫反応を高めてがん細胞を殺すのを助ける薬剤が含まれます。標的療法薬は、がんの増殖を促進する特定のタンパク質またはがん細胞を攻撃します。
頭頸部扁平上皮がんは、喉の構造に影響を与えるだけではありません。また、次のような頭と首の他の領域にも発症する可能性があります。
- 唇
- 舌
- 鼻腔
- 副鼻腔
頭頸部の扁平上皮癌は体の他の部分に転移する可能性があります。ほとんどの場合、局所的に広がるか、首のリンパ節に広がります。
咽頭扁平上皮癌に関してよくある質問をいくつか紹介します。
咽頭扁平上皮癌はどの程度深刻ですか?
咽頭扁平上皮癌は重篤な状態です。場合によっては、人の会話、食事、呼吸の能力に影響を与える可能性があります。生命を脅かす可能性もあります。
しかし、正確な診断を受け、できるだけ早く治療を開始することが予後を改善するのに役立つ可能性があります。
咽頭扁平上皮癌の生存率はどれくらいですか?
咽頭扁平上皮癌の生存率は、癌の段階と腫瘍の位置によって異なります。喉の外側に転移していない局所がんを患っている人は、通常、進行がんを患っている人よりも予後が良好です。
たとえば、米国癌協会によると、喉頭に限局性がんがある人の 5 年相対生存率は 59 ~ 84% です。がんが離れた部位に転移している場合、5 年相対生存率は 30 ~ 45% です。
継続的な研究により咽頭扁平上皮癌患者の治療法が改善され、生存率が向上する可能性があります。また、人によって考え方が異なることを覚えておくことも重要です。
相対生存率は、特定の疾患のある人が、診断を受けた後にその疾患のない人と比較してどれくらい生存できるかを知るのに役立ちます。
たとえば、5 年相対生存率が 70% の場合、この疾患のある人は、疾患のない人に比べて 5 年間生存する可能性が 70% 高いことを意味します。
これらの数値は推定値であることを覚えておくことが重要です。自分の状態が自分にどのような影響を与えるかについて医療専門家に相談できます。
喉の扁平上皮癌は、喉の内側を覆う細胞で発生する癌の一種です。発声器、扁桃腺、喉頭蓋に発生する場合があります。症状としては、喉の痛みや嚥下困難などがよくみられます。
喫煙は喉の扁平上皮癌の主な危険因子の 1 つです。その他の危険因子としては、大量のアルコール摂取や HPV 感染などが挙げられます。
喉の扁平上皮がんの症状に不安を感じたら、すぐに医師に相談するのが最善です。医師は診断を確定するために検査を指示し、手術や放射線療法などの適切な治療法についてアドバイスすることができます。
喉に影響を及ぼす頭頸部扁平上皮がんについて知っておくべきこと・関連動画
参考文献一覧
- https://www.cancer.org/cancer/types/laryngeal-and-hypopharyngeal-cancer/detection-diagnosis-staging/survival-rates.html
- https://www.cancer.org/cancer/types/laryngeal-and-hypopharyngeal-cancer/causes-risks-prevention/risk-factors.html
- https://www.ncbi.nlm.nih.gov/books/NBK563268/#article-113372.s9
- https://www.cdc.gov/cancer/hpv/basic_info/hpv_oropharyngeal.htm
- https://www.cdc.gov/cancer/headneck/index.htm
- https://www.ncbi.nlm.nih.gov/books/NBK563268/#article-113372.s8
- https://www.cancer.org/cancer/types/laryngeal-and-hypopharyngeal-cancer/causes-risks-prevention/what-causes.html
- https://www.cancer.gov/types/head-and-neck/hp/social/laryngeal-treatment-pdq